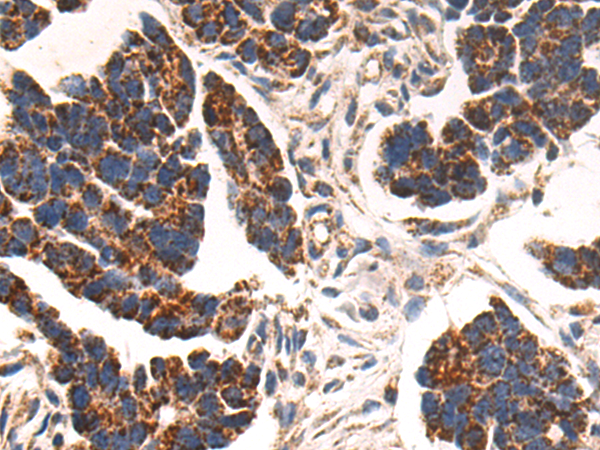
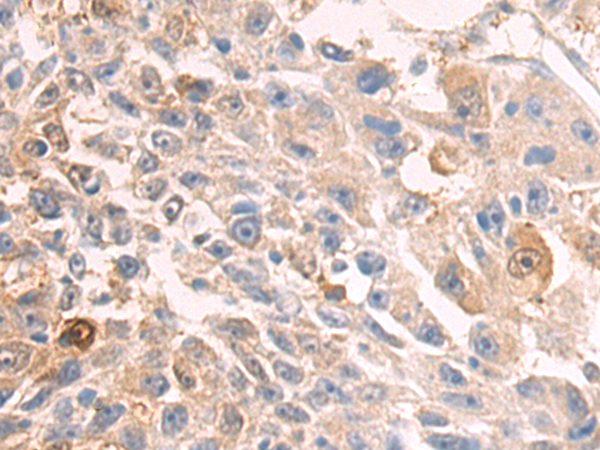
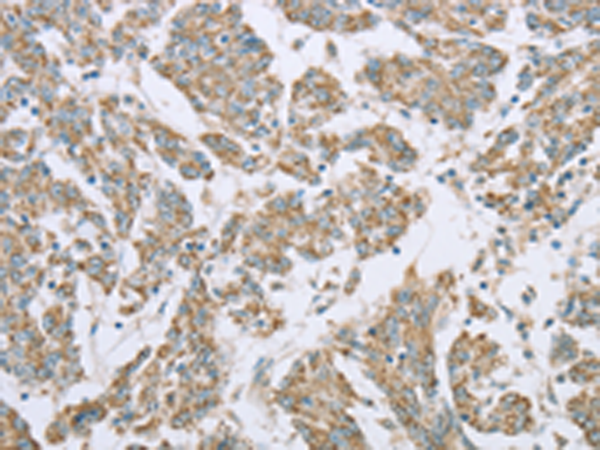

-
分类: 科研抗体货号: P08287别名: EPDR; UCC1; MERP1; MERP-1应用: WB,IHC反应种属: Human, Mouse, Rat
-
分类: 科研抗体货号: P08266别名: EF2; EF-2; EEF-2; SCA26应用: WB,IHC反应种属: Human, Mouse, Rat
-
分类: 科研抗体货号: P08286别名: PCPH; CD39L4; NTPDase-5应用: WB,IHC反应种属: Human, Mouse, Rat
-
分类: 科研抗体货号: P08265别名: DEL1应用: WB,IHC反应种属: Human, Mouse
-
分类: 科研抗体货号: P08284别名: PHA1; BESC3; ENaCg; LDLS2; SCNEG; ENaCgamma应用: IHC反应种属: Human, Mouse, Rat
-
分类: 科研抗体货号: P08264别名: XEDAR; EDAA2R; EDA-A2R; TNFRSF27应用: WB,IHC反应种属: Human
-
分类: 科研抗体货号: P08282别名: Ssc1; CGI-88应用: WB,IHC反应种属: Human, Mouse
-
分类: 科研抗体货号: P08262别名: ECP; RNS3应用: WB,IHC反应种属: Human
-
分类: 科研抗体货号: P08281别名: SIII; TCEB2应用: IHC反应种属: Human, Mouse, Rat
-
分类: 科研抗体货号: P08261别名: SCEH应用: WB,IHC反应种属: Human, Mouse, Rat

鄂公网安备42018502007531号
鄂公网安备42018502007531号

